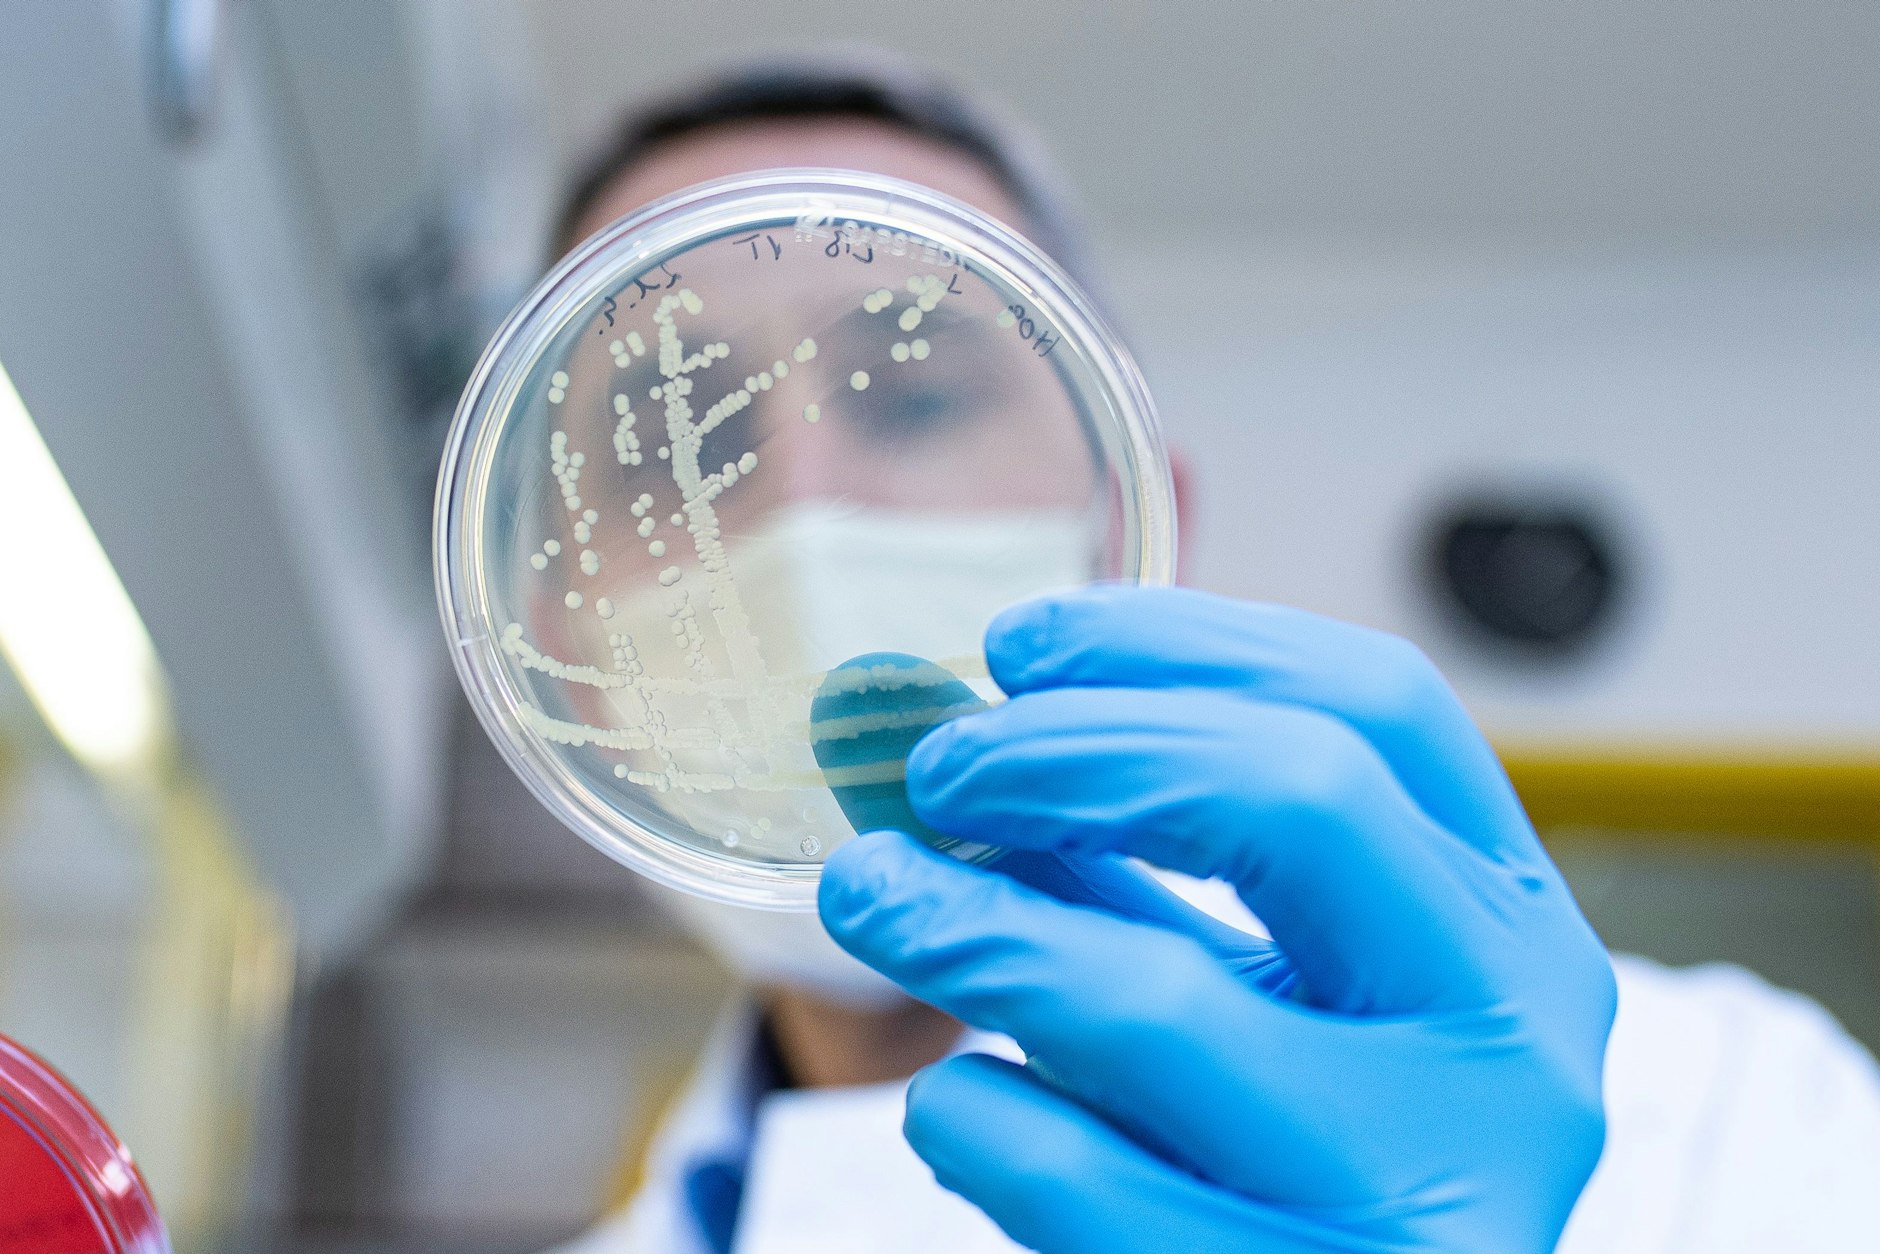
Der Ehec-Ausbruch in Mecklenburg-Vorpommern weitet sich aus: Schon sechs Kinder haben sich in Berlin mit dem Darmkeim angesteckt (Symbolfoto).

Der Ehec-Ausbruch in Mecklenburg-Vorpommern: Er hat auch immer mehr Folgen für Berlin! Laut neuester Informationen sind inzwischen bereits sechs Kinder aus Berlin betroffen, außerdem ein Kind aus Brandenburg. Sie verbrachten Zeit in Mecklenburg-Vorpommern, infizierten sich dort offenbar mit dem gefährlichen Darmkeim.
Ausbruch in den Ferien: Schon sechs Kinder in Berlin mit Ehec infiziert
Laut Angaben des Landesamtes für Gesundheit und Soziales (Lageso) in Berlin handelt es sich bisher um fünf Kinder im Alter bis zu drei Jahren und ein Kind zwischen 3 und 16 Jahren. Die genauen Altersangaben der betroffenen Kinder sind nicht bekannt. Drei der Kinder hätten bereits mit dem hämolytisch-urämischen Syndrom (HUS) zu kämpfen – es wird durch die Ehec-Erreger ausgelöst, kann unter anderem Störungen bei der Blutgerinnung und Funktionsstörungen der Nieren hervorrufen.

Außerdem gibt es zwei weitere Kinder, die an HUS leiden, allerdings gibt es hier keinen Zusammenhang mit dem Ehec-Ausbruch in Mecklenburg-Vorpommern. Alle Kinder, bei denen HUS auftauchte, seien in Krankenhäusern behandelt worden. Auch das Kind aus Brandenburg bekam das Syndrom, wird aktuell in einer Klinik in Leipzig behandelt. Der Gesundheitszustand des kleinen Patienten sei stabil, hieß es aus dem Gesundheitsministerium Brandenburg.
Rinder und Ziegen: Beim Streicheln kann man sich bei den Tieren mit Ehec anstecken
In Mecklenburg-Vorpommern hatten sich in den Sommerferien mehr als 20 Kinder und Jugendliche mit den Keimen infiziert. Der Begriff Ehec steht für „enterohämorrhagische Escherichia coli“ – darunter fasst man die Stämme eines Darmbakteriums zusammen, die unter anderem bei Tieren wie Rindern und Ziegen vorkommen. Während sie bei den Tieren keinen Schaden anrichten, können sich Menschen etwa beim Streicheln der Tiere damit infizieren. Die Folge können unter anderem schwere Durchfallerkrankungen sein.